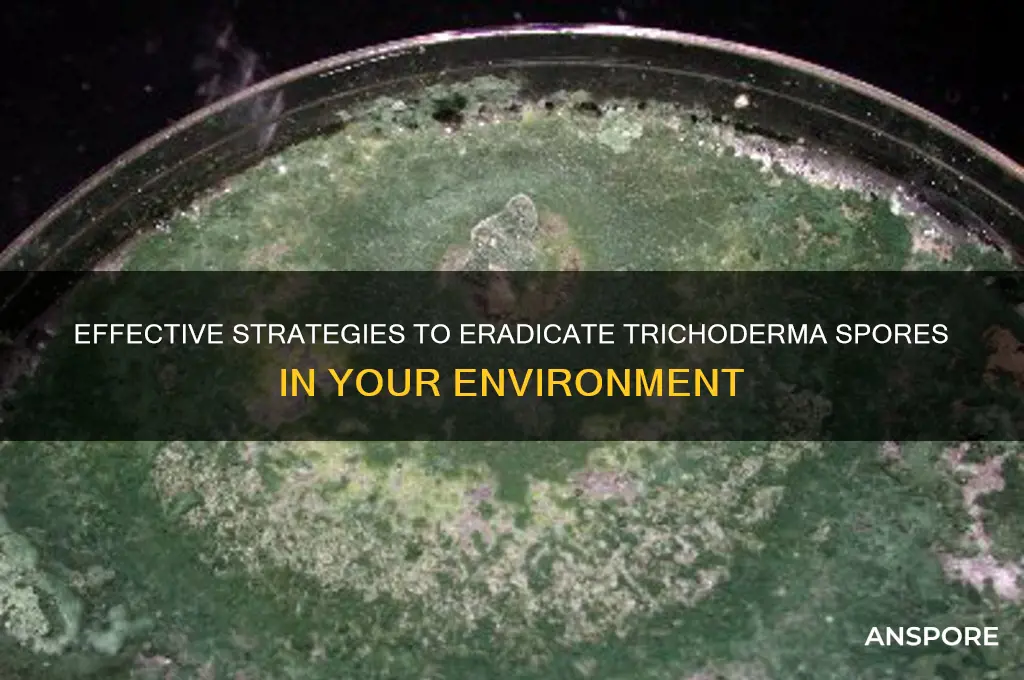
how to kill trichoderma spores

Trichoderma spores, commonly found in soil and organic matter, can be problematic in various settings, including agriculture, horticulture, and indoor environments, as they may compete with beneficial microorganisms or cause contamination. To effectively kill Trichoderma spores, a combination of physical, chemical, and environmental methods is often necessary. Physical approaches include heat treatment, such as exposing materials to temperatures above 60°C (140°F) for extended periods, or using filtration systems to remove spores from air or water. Chemical methods involve the application of fungicides like hydrogen peroxide, sodium hypochlorite, or specialized biocides that target spore structures. Additionally, maintaining low humidity levels and ensuring proper ventilation can inhibit spore germination and growth. For surfaces, thorough cleaning and disinfection are crucial, while in soil or plant media, pasteurization or sterilization techniques can be employed. Consistent monitoring and preventive measures are essential to minimize Trichoderma spore proliferation and mitigate their impact.
| Characteristics | Values |
|---|---|
| Temperature | Exposure to temperatures above 60°C (140°F) for at least 30 minutes. |
| Chemical Agents | Sodium hypochlorite (bleach), hydrogen peroxide, ethanol, or formaldehyde. |
| pH Levels | Extreme pH conditions (below 3 or above 10) can inactivate spores. |
| UV Radiation | Prolonged exposure to UV-C light (254 nm) can disrupt spore DNA. |
| Autoclaving | Effective at 121°C (250°F) and 15 psi for 15-30 minutes. |
| Desiccation | Spores are more resistant to desiccation but can be reduced over time. |
| Filtration | HEPA filters (0.3 µm) can physically remove spores from air or liquids. |
| Ozone Treatment | Ozone gas can be used to kill spores in controlled environments. |
| Gamma Irradiation | High doses of gamma radiation can inactivate spores. |
| Biological Control | Antagonistic microorganisms or enzymes that target Trichoderma spores. |
| Storage Conditions | Spores can survive for years in dry, cool, and dark conditions. |
| Resistance | Trichoderma spores are highly resistant to many common disinfectants. |
| Surface Disinfection | Thorough cleaning followed by application of effective chemical agents. |
| Avoiding Cross-Contamination | Use sterile techniques and disposable tools to prevent spore spread. |
What You'll Learn
- Heat Treatment Methods: Effective temperatures and durations to eliminate Trichoderma spores in various materials
- Chemical Disinfectants: Suitable chemicals and concentrations for spore eradication in different environments
- UV Light Exposure: Optimal UV wavelengths and exposure times to neutralize Trichoderma spores
- Filtration Techniques: Air and liquid filtration systems to remove and prevent spore spread
- Environmental Control: Humidity and pH adjustments to inhibit Trichoderma spore survival and growth

Heat Treatment Methods: Effective temperatures and durations to eliminate Trichoderma spores in various materials
Trichoderma spores are notoriously resilient, but heat treatment stands out as one of the most effective methods to eliminate them. The key lies in applying the right temperature for the appropriate duration, tailored to the material being treated. For instance, in agricultural settings, soil infested with Trichoderma can be treated by heating it to 60°C (140°F) for at least 30 minutes. This method is both practical and cost-effective, making it a go-to solution for farmers combating fungal contamination.
When dealing with more delicate materials, such as plant tissues or organic matter, precision is crucial. Exposing these materials to temperatures above 70°C (158°F) for 10–15 minutes can effectively kill Trichoderma spores without causing significant damage. However, it’s essential to monitor the process closely, as prolonged exposure to high heat can degrade the material’s quality. For example, in the case of compost, heating to 65°C (149°F) for 24 hours ensures thorough spore eradication while preserving the compost’s beneficial properties.
In industrial applications, such as treating wooden materials or construction supplies, higher temperatures are often necessary. Subjecting wood to 80°C (176°F) for 1–2 hours has proven effective in eliminating Trichoderma spores. This method is particularly useful in preventing fungal growth in structural materials, which can compromise their integrity over time. However, caution must be exercised to avoid overheating, as this can warp or damage the wood.
For liquid media, such as nutrient solutions or hydroponic systems, heat treatment requires a different approach. Heating the liquid to 65°C (149°F) for 30 minutes is generally sufficient to kill Trichoderma spores. It’s important to stir the liquid continuously during treatment to ensure uniform heat distribution. This method is widely used in greenhouse operations to prevent fungal outbreaks in irrigation systems.
While heat treatment is highly effective, it’s not a one-size-fits-all solution. Factors such as material type, moisture content, and spore density influence the required temperature and duration. For instance, materials with high moisture content may require longer treatment times due to the insulating effect of water. Always test a small sample before treating the entire batch to ensure the method is both effective and safe for the material in question. With careful application, heat treatment remains a reliable and accessible tool in the fight against Trichoderma spores.
Quick Guide: Checking Your Spore Game Version Easily
You may want to see also

Chemical Disinfectants: Suitable chemicals and concentrations for spore eradication in different environments
Trichoderma spores, known for their resilience, pose a challenge in various environments, from laboratories to agricultural settings. Chemical disinfectants offer a targeted solution, but efficacy depends on selecting the right agent and concentration. Sodium hypochlorite, commonly known as bleach, is a frontline option. A 5–10% solution effectively eradicates spores on surfaces, though prolonged exposure—at least 30 minutes—is critical for success. However, bleach’s corrosiveness limits its use on sensitive materials, necessitating alternatives like hydrogen peroxide or peracetic acid in such cases.
In healthcare and laboratory settings, where precision is paramount, hydrogen peroxide stands out. At concentrations of 6–7%, it penetrates spore coats and disrupts cellular structures, achieving sterilization within 30–60 minutes. Its compatibility with metals and plastics makes it ideal for equipment decontamination. For agricultural environments, where large-scale application is common, peracetic acid offers a potent yet biodegradable option. A 0.2–0.5% solution effectively treats soil and irrigation systems, balancing spore eradication with environmental safety.
When addressing water systems, chlorine dioxide emerges as a superior choice. Its 2–5 ppm concentration neutralizes spores without leaving harmful residues, making it suitable for drinking water treatment. However, its instability requires on-site generation, adding complexity to implementation. In contrast, ethanol, while widely available, is less effective against spores even at 70% concentration, underscoring the need for specialized agents in spore control.
Practical application demands caution. Always pre-clean surfaces to remove organic matter, which can shield spores from disinfectants. Monitor contact time rigorously, as insufficient exposure undermines efficacy. For porous materials, consider steam sterilization as a chemical-free alternative. Ultimately, the choice of disinfectant hinges on the environment, material compatibility, and scale of application, ensuring both safety and spore eradication.
Removing Mole Spores from Lungs: Effective Treatments and Prevention Tips
You may want to see also

UV Light Exposure: Optimal UV wavelengths and exposure times to neutralize Trichoderma spores
Ultraviolet (UV) light exposure is a proven method for neutralizing Trichoderma spores, leveraging its ability to damage nucleic acids and disrupt cellular functions. Among the UV spectrum, UVC light (200–280 nm) is the most effective due to its high energy, with wavelengths around 254 nm being particularly lethal to microorganisms. This wavelength penetrates the spore’s cell wall, causing thymine dimerization in DNA, which prevents replication and renders the spore non-viable. For optimal results, UVC light at 254 nm is the gold standard in spore neutralization.
To effectively neutralize Trichoderma spores using UV light, exposure time and intensity must be carefully calibrated. Studies indicate that a dose of 30–50 mJ/cm² is sufficient to achieve a 99% reduction in spore viability. This can be achieved with a 15–30 minute exposure to a standard UVC lamp emitting 1 mW/cm². However, factors such as distance from the light source, spore concentration, and environmental conditions (e.g., humidity) can influence efficacy. For instance, spores suspended in liquid may require longer exposure times compared to those on dry surfaces due to reduced light penetration.
Practical implementation of UV treatment requires precision and safety precautions. UVC lamps should be positioned at a consistent distance from the target area to ensure uniform exposure. For surface disinfection, a distance of 15–30 cm is recommended, while liquid treatments may require stirring to ensure all spores receive adequate exposure. It’s critical to avoid direct human exposure to UVC light, as it can cause skin and eye damage. Using automated systems or protective gear is essential for safe operation.
Comparing UV treatment to other methods, such as chemical disinfectants or heat, highlights its advantages and limitations. Unlike chemicals, UV light leaves no residue and is environmentally friendly, making it ideal for sensitive applications like food processing or laboratory settings. However, its effectiveness is limited by line-of-sight—UV light cannot neutralize spores in shadows or behind obstacles. Combining UV treatment with other methods, such as filtration or mild heat, can enhance overall efficacy, particularly in complex environments where spores may be shielded from direct light.
In conclusion, UV light exposure, specifically UVC at 254 nm, is a powerful tool for neutralizing Trichoderma spores when applied correctly. By adhering to optimal wavelengths, dosages, and safety protocols, this method offers a reliable and residue-free solution for spore control. While it may not be a standalone answer in all scenarios, its integration into broader disinfection strategies can significantly improve outcomes, particularly in industries where precision and safety are paramount.
Mastering Spore Sax Acquisition: A Comprehensive Guide for Enthusiasts
You may want to see also

Filtration Techniques: Air and liquid filtration systems to remove and prevent spore spread
Trichoderma spores, ubiquitous in various environments, pose challenges in industries ranging from agriculture to pharmaceuticals due to their resilience and rapid proliferation. Filtration techniques emerge as a critical line of defense, offering both air and liquid filtration systems to intercept and neutralize these spores before they spread. By employing specialized filters, such as HEPA (High-Efficiency Particulate Air) filters for air and membrane filters for liquids, facilities can maintain sterile conditions essential for sensitive processes. These systems not only remove spores but also prevent their reintroduction, ensuring long-term contamination control.
In air filtration, HEPA filters are the gold standard, capturing particles as small as 0.3 microns with an efficiency of 99.97%. For environments requiring even higher purity, such as cleanrooms, ULPA (Ultra-Low Particulate Air) filters can be employed, trapping particles down to 0.12 microns. Proper installation and regular maintenance are critical; filters must be replaced according to manufacturer guidelines, typically every 6–12 months, depending on usage and environmental conditions. Additionally, pre-filters can extend the lifespan of HEPA/ULPA filters by capturing larger particles, reducing the load on the primary filtration system.
Liquid filtration systems, on the other hand, rely on membrane filters to remove Trichoderma spores from water, nutrient solutions, or other liquids. Membranes with pore sizes of 0.22 microns or smaller are effective in trapping spores while allowing the passage of liquids. For example, in biopharmaceutical production, sterile filtration using 0.22-micron PES (polyethersulfone) or PVDF (polyvinylidene fluoride) membranes is standard practice. It’s essential to monitor differential pressure across the filter to detect clogging, which can compromise flow rates and filtration efficiency. Regular integrity testing, such as bubble point or water intrusion tests, ensures the filter remains intact and functional.
A comparative analysis reveals that while air filtration focuses on continuous operation to maintain sterile environments, liquid filtration is often a batch process, applied at specific stages of production. Air systems are designed for high throughput, handling large volumes of air per minute, whereas liquid systems prioritize precision, ensuring no spores pass through even in small batches. Both, however, share the common goal of spore removal and require meticulous planning and execution to be effective.
In practice, integrating filtration systems into existing workflows demands careful consideration. For instance, in indoor farming, air filtration units should be strategically placed near intake vents to prevent spore entry, while liquid filters must be installed at critical points like irrigation systems. Combining filtration with complementary methods, such as UV-C light treatment for air or chemical disinfectants for liquids, can enhance efficacy. Ultimately, filtration techniques are not just about removing spores but about creating a holistic barrier that safeguards processes and products from Trichoderma contamination.
Can Vinegar Effectively Kill C. Diff Spores? Facts and Myths
You may want to see also

Environmental Control: Humidity and pH adjustments to inhibit Trichoderma spore survival and growth
Trichoderma spores thrive in environments with high humidity and neutral pH levels, making these conditions prime targets for control strategies. By manipulating these factors, you can create an inhospitable environment that inhibits spore germination and mycelial growth. This approach is particularly effective in agricultural and indoor cultivation settings where Trichoderma can cause significant damage to crops and plants.
Analytical Perspective:
Humidity levels above 80% and pH ranges between 5.5 and 8.0 are optimal for Trichoderma spore survival. Reducing relative humidity below 60% disrupts the water availability necessary for spore activation, while maintaining a pH outside this range—either highly acidic (below 4.5) or alkaline (above 8.5)—can denature essential enzymes required for spore metabolism. For instance, in controlled environments like greenhouses, using dehumidifiers and pH-adjusting agents such as sulfuric acid or lime can effectively suppress Trichoderma proliferation. Studies show that a 20% reduction in humidity can decrease spore viability by up to 50% within 48 hours.
Instructive Steps:
To implement environmental control, start by monitoring humidity and pH levels daily using digital hygrometers and pH meters. For humidity reduction, install dehumidifiers or increase ventilation in enclosed spaces. In soil-based systems, ensure proper drainage to prevent waterlogging. To adjust pH, apply diluted vinegar (acetic acid) for acidification or baking soda (sodium bicarbonate) for alkalization. For example, mixing 1 tablespoon of vinegar per gallon of water can lower soil pH by 0.5 units. Always test pH after adjustments to avoid over-correction, which could harm beneficial microorganisms.
Comparative Insight:
Unlike chemical fungicides, which may leave residues or promote resistance, environmental control offers a sustainable and non-toxic alternative. While fungicides act directly on spores, humidity and pH adjustments create systemic barriers that prevent spore establishment. For instance, in hydroponic systems, maintaining a pH of 4.0–4.5 not only inhibits Trichoderma but also enhances nutrient uptake in plants like lettuce and strawberries. This dual benefit highlights the efficiency of environmental manipulation over reactive treatments.
Practical Tips:
In indoor growing environments, use silica gel packets or moisture-absorbent materials to passively reduce humidity. For pH management, incorporate organic matter like peat moss (acidic) or wood ash (alkaline) into the substrate. Regularly clean and disinfect equipment to prevent spore introduction. In large-scale operations, automate humidity and pH control using smart sensors and dosing systems to maintain consistency. For outdoor applications, consider mulching to regulate soil moisture and pH, especially in regions with high rainfall or alkaline soils.
Environmental control through humidity and pH adjustments is a proactive, cost-effective strategy to inhibit Trichoderma spore survival and growth. By understanding the specific thresholds that Trichoderma requires, growers can tailor their environments to suppress this fungus while promoting plant health. Implementing these measures not only mitigates crop losses but also reduces reliance on chemical interventions, fostering more sustainable agricultural practices.
Releasing Spores into the Wild: Risks, Ethics, and Environmental Impact
You may want to see also
Frequently asked questions
The most effective method to kill Trichoderma spores is through a combination of heat treatment and chemical disinfection. Exposing the spores to temperatures of 121°C (250°F) for at least 30 minutes in an autoclave is highly effective. Alternatively, using disinfectants like hydrogen peroxide, bleach, or quaternary ammonium compounds can also kill spores when applied correctly.
Yes, Trichoderma spores can survive in soil for extended periods. To eliminate them, solarization (covering moist soil with clear plastic to heat it under sunlight) or chemical fumigation with approved soil sterilants like chloropicrin or metam sodium can be effective.
UV light can reduce Trichoderma spore viability but is not as effective as heat or chemical methods. Prolonged exposure to UV-C light (254 nm) may damage spores, but it is not a reliable standalone method for complete eradication.
Surfaces and equipment can be disinfected using 70% ethanol, 10% bleach solution, or commercial disinfectants specifically designed to kill fungal spores. Ensure thorough cleaning to remove organic matter before disinfection, as it can protect spores from chemicals.







